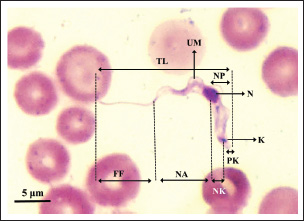

| Research Article | ||
Open Vet. J.. 2025; 15(7): 3254-3268 Open Veterinary Journal, (2025 ), Vol. 15(7): 3254-3268 Research Article Morphometrics analysis and molecular identification of the Trypanozoon from IndonesiaDidik Tulus Subekti1,2, Lucia Tri Suwanti3*, Sunarno Sunarno2, Mufasirin Mufasirin3, Endang Suprihati3, Iwan Sahrial Hamid4, Eduardus Bimo Aksono Herupradoto4 and Emy Koestanti Sabdoningrum51Veterinary Science Program, Faculty of Veterinary Medicine, Airlangga University, Surabaya, Indonesia 2Center for Biomedical Research, Research Organization for Health, National Research and Innovation Agency, Cibinong Science Center, Bogor, Indonesia 3Division of Veterinary Parasitology, Faculty of Veterinary Medicine, Airlangga University, Surabaya, Indonesia 4Division of Basic Veterinary Science, Faculty of Veterinary Medicine, Airlangga University, Surabaya, Indonesia 5Division of Animal Husbandry, Faculty of Veterinary Medicine, Airlangga University, Surabaya, Indonesia *Corresponding Author: Lucia Tri Suwanti. Division of Veterinary Parasitology, Faculty of Veterinary Medicine, Airlangga University, Surabaya, Indonesia. Email: lucia-t-s [at] fkh.unair.ac.id Submitted: 31/01/2025 Revised: 18/06/2025 Accepted: 20/06/2025 Published: 31/07/2025 © 2025 Open Veterinary Journal
ABSTRACTBackground: Morphologically, the species within the subgenus Trypanozoon cannot be clearly distinguished. Aim: To identify and characterize trypanosome species in Indonesia through a molecular algorithm that was carried out in stages using four pairs of primers to confirm and distinguish between species of the subgenus Trypanozoon. Methods: A total of 28 trypanosome isolates were examined microscopically, and their morphobiometrics were observed. The isolates were also identified molecularly with an identification algorithm involving four pairs of primers in a hierarchical manner, namely, ITS1, ESAG6/7, minicircle, and maxicircle. Results: Morphologically, Indonesian trypanosomes are characterized by a long, slender shape, small kinetoplasts located below the posterior terminal end, and free flagella with conspicuous undulating membranes. Screening using ITS1 and ESAG6/7 showed a single band at 480 and 237 bp, which indicates the subgenus Trypanozoon species identification using minicircle primer followed by maxicircle primer showed that Indonesian trypanosomes are Trypanosoma (Trypanozoon) evansi (T. evansi) and Trypanosoma (Trypanozoon) equiperdum (T. equiperdum). Indonesian T. evansi has a total body length of 26.45 μm (22.79–29.04 μm) with the kinetoplast positioned at 1.73 μm from the posterior end, while Indonesian T. equiperdum has a body length of 26.41 μm (22.83–30.89 μm) and the kinetoplast positioned at 1.91 μm from the posterior end. Conclusions: Molecular identification algorithms can distinguish species of the subgenus Trypanozoon more accurately than morphobiometric observations. Trypanozoon species found in Indonesia include Trypanosoma evansi and Trypanosoma equiperdum. Clinical Relevance: The minicircle and maxicircle primers are the key to species identification of Trapanozoon which can be applied to overcome the identification difficulties that have been experienced so far. Keywords: Algorithm, Molecular identification, Morphometric, Trypanosoma evansi, Trypanosoma equiperdum. IntroductionTrypanosomiasis is a fatal parasitic disease caused by protozoa belonging to the genus Trypanosoma (Baral, 2010). Two forms of the disease found in Asia and Africa are surra [caused by Trypanosoma (Trypanozoon) evansi] and dourine [caused by Trypanosoma (Trypanozoon) equiperdum] (Gizaw et al., 2017; Desquesnes et al., 2022). Trypanosomiasis causes enormous economic losses and death in buffalo, horse, and other animals. In general, the losses caused by trypanosomiasis have been estimated to reach US$1,699,731 in East Nusa Tenggara province of Indonesia and as much as US$ 223,164,000 nationwide in Somalia (Salah et al., 2015; Dewi et al., 2020; Subekti et al., 2024a). Furthermore, some species, such as Trypanosoma (Schizotrypanum) cruzi and Trypanosoma (Trypanozoon) brucei, can infect humans, causing Chagas disease and sleeping sickness (Austen and Barbosa, 2021; Magri et al., 2021; Desquesnes et al., 2022; Ortiz-Martínez et al., 2023). In view of these significant effects, accurate species identification will be useful for disease diagnosis and estimating the risk of disease transmission, and economic losses. However, one obstacle to species identification is their morphological similarity, especially in the subgenus Trypanozoon (Li et al., 2006; Sánchez et al., 2016; Wen et al., 2016; WOAH, 2021). Trypanosoma (Trypanozoon) evansi (T. evansi), Trypanosoma (Trypanozoon) equiperdum (T. equiperdum), and T. (Trypanozoon) brucei (T. brucei) belong to the subgenus Trypanozoon (Richardson et al., 2017; Benfodil et al., 2020; Oldrieve et al., 2021). This situation has persisted for a long time, as reported by Hoare (1956) and Bruce (1911). An alternative method for identifying species within the Trypanozoon subgenus using a molecular approach. Researchers have published a number of widely used primers, including ITS1, TRYP1, RoTat 1.2, ESAG6/7, TBR, and TEPAN (WOAH, 2021). The use of each primer cannot distinguish between trypanosomes at the species level. ITS1 and TRYP1 primers differentiate several trypanosomes based on their amplicon size, such as Trypanosoma (Nannomonas) congolense (T. congolense), Trypanosoma (Nannomonas) simiae (T. simiae), Trypanosoma (Nannomonas) godfreyi (T. godfreyi), Trypanosoma (Duttonella) vivax (T. vivax), Trypanosoma (Megatrypanum) theileri (T. theileri), and the subgenus Trypanozoon (Njiru et al., 2005; Gaithuma et al., 2019; Marsela et al., 2020; WOAH, 2021; Suganuma et al., 2022). The other four primers (i.e., RoTat 1.2, ESAG6/7, TBR, TEPAN) were only able to identify up to the Trypanozoon subgenus level (Benfodil et al., 2020; Habeeb et al., 2021; WOAH, 2021). None of these primers is singularly species-specific. However, some researchers have insisted that these primers be used for the specific identification of T. evansi, both abroad and in Indonesia. This mistake has led to misidentification of the subgenus Trypanozoon, which was previously claimed to be T. evansi. Several reports that have the potential for misidentification, such as Sawitri et al. (2015), used ITS-1, Ro Tat 1.2, and ESAG 6/7 primers. Likewise, Bono-Battistoni et al. (2016), Dangolla et al. (2020), and Boutellis et al. (2021) used the ITS1 primer, whereas Setiawan et al. (2021) used the ITS2 primer. Jaimes-Dueñez et al. (2022) also misidentified T. evansi using the ESAG6/7 primer. Therefore, a molecular identification algorithm is needed as an integrated approach to avoid misidentification of Trypanozoon. It has been reported that a primer targeting the minicircle gene can distinguish T. evansi and T. equiperdum from T. brucei (Artama et al., 1992; Subekti et al., 2023). On the other hand, a primer targeting the maxicircle nad5 gene has also been reported to distinguish T. equiperdum and T. brucei from T. evansi (Li et al., 2007; Suganuma et al., 2022; Subekti et al., 2023). Based on this background, this study combined both approaches (morphological, biometry, and molecular) in a systematic and complementary manner for species identification of Trypanozoons using a tiered approach using a molecular algorithm. Materials and MethodsOrigin of isolatesThe 28 Trypanosoma sp isolates used in this study originated from several areas of Indonesia (Table 1). The isolates were stored at the Balitvet Culture Collection, Indonesian Research Center for Veterinary Science, Bogor, Indonesia. The trypanosomes from abroad that were used in this study were T. evansi (accession numbers M57459, M57460, M57461, M57462, M81594, M34848, AY918061, JX866700, JX869940, AF165116, ON855347, ON855348, and ON855349), T. brucei (accession numbers M15324, M17997, KF293288, L16543, and V01388), and T. equiperdum (accession numbers M14763, M63982, EU155057, EU155058, and JX869938). All are available in the database of the National Center for Biotechnology Information (NCBI) GenBank (https://www.ncbi.nlm.nih.gov/genbank). Morphological methodTrypanosome thin blood smears were prepared and stained with Romanowsky dye using MDT stain (Indoreagen, Jakarta, Indonesia). Thin blood slides were then examined under a Nikon Eclipse Ni microscope (Nikon, Tokyo, Japan), and morphometric measurements were made using NIS Elements version 4.40 imaging software (Nikon, Tokyo, Japan). Each isolate was subjected to morphometric measurements from three individuals on each slide. The morphological identification algorithm followed the guidelines summarized in Figure 1, while the biometric measurements were guided by Figure 2. Molecular methodTrypanosoma were purified by anion exchange chromatography using a Toyopearl 650M (Tosoh Bioscience, Philadelphia, PA), as previously described (Subekti et al., 2024a). The genomic DNA of purified trypanosomes was extracted using DNAzol (Molecular Research Center Inc., Cincinnati, OH) according to the manufacturer’s instructions. All genomic DNA of the trypanosomes was amplified using an Applied Biosystems™ 2720 Thermal Cycler (Applied Biosystems, Waltham, MA). Polymerase chain reaction (PCR) was conducted using a mixture with a volume of 50 µl [1 µl (100 ng/µl) DNA, 1 µl (20 µm) of each primer (forward and reverse)], 25 µl of MyTaq™ HS Red Mix 2× (Meridian Life Science Inc., Memphis, TN), and 22 µl of nuclease-free water. The amplification protocol for each primer followed the instructions in Table 2. The PCR products were then electrophoresed in a 1.5% agarose gel with SYBR Safe DNA stain (Invitrogen, Thermo Fisher Scientific Inc., Waltham, MA) using the RunVIEW real-time gel visualization system (Cleaver Scientific Ltd., Warwickshire, UK) and visualized using a Clear View UV Transilluminator (Cleaver Scientific Ltd.). The PCR products were also sent to Bioneer Corp., for PCR product purification and sequencing (Bioneer Corp., Daejeon, Republic of Korea). All DNA sequences were compared with those of other trypanosomes using the basic local alignment search tool from the NCBI. Table 1. Indonesian isolate of Trypanosoma sp used in this study
The molecular identification algorithm follows the steps presented in Figure 1 (Subekti et al., 2025). First step, the DNA of all isolates was subjected to PCR using the primers ITS1 followed by ESAG6/7. The ITS1 primer aims to detect a mixture of Trypanosoma spp or not. Amplification results for single amplicons with lengths of 480 base pairs indicated the subgenus Trypanozoon. The results of amplification with ESAG6/7 primers at a length of 237 base pairs strengthen the indication that the isolate was from the subgenus Trypanozoon. In the second stage, each isolate identifed as Trypanozoon was subjected to PCR using Mini primer followed by Maxi primer. If the amplification result with Mini primer was negative, then the isolate was likely T. brucei group or akinetoplastic Trypanozoon. Conversely, if the amplification result was positive, the isolate was likely T. evansi or T. equiperdum. Positive PCR with Mini primer was continued using Maxi primer. The positive result was identified as T. equiperdum; otherwise, it was identified as T. evansi. The same steps were also performed using negative PCR with a Mini primer (Fig. 1). Phylogenetic and hierarchical cluster analysisNucleotide sequence alignment was conducted using CLC Sequence Viewer 8 (CLC bio-Qiagen, Aarhus, Denmark). Dendrograms were constructed using the unweighted pair group method with arithmetic means (UPGMA) with nucleotide distance measure Kimura-80 parameter using the CLC Sequence Viewer and bootstrap analysis of 1,000 replicates. The Interactive Tree of Life (https://itol.embl.de/itol.cgi) was used for dendrogram visualization. Hierarchical cluster analysis (HCA) for dendrogram construction was performed using the complete linkage method (farthest neighbor clustering) with Minitab Version 16 (Minitab, State College, PA).
Fig. 1. Algorithm of morphological and molecular identification of mammalian trypanosomes. Stepwise molecular identification for species determination of Trypanozoon. ITS1 primers for screening, ESAG6/7 for confirmation, Mini primer (for gRNA of minicircle gene) followed by Maxi primer (for nd5-kDNA of maxicircle gene) for species differentiation. Magenta is the result of PCR using Mini primer, Green is the result of PCR using Maxi primer (partly adapted and modified from Subekti et al., 2025).
Fig. 2. Morphological measurements (morphometrics) guide of Trypanozoon subgenus. BL=body length (BL=NA + NP); FF=free flagella; K=kinetoplast; N=nucleus; NA=nucleus to anterior end; NK=nucleus to kinetoplast; NP=nucleus to posterior end; NPR=nucleus position ratio (NPR=NP/NA); PK=posterior end to kinetoplast; TL=total length; UM=undulating membrane. ResultsMorphometric identificationMicroscopic observations revealed morphological features in the form of small subterminal or nearly terminal kinetoplasts at a distance of 1.82 μm (0.17–2.73 μm) from the posterior end. The parasite’s shape is long and slender, with an average total length of 26.43 μm (22.79–30.89 μm), as summarized in Table 3. These morphometric characteristics are also similar to recent studies that have reported that the trypomastigote form of Trypanozoon in the blood is long and slender, with the nucleus located in the center, with the position of the kinetoplast sub-terminal from the posterior end (about 1.4 μm from the posterior end), and has a total body length of 24.9 μm (16.9–31.3 μm), and even the kinetoplast distance can reach 4 μm from the posterior end (Uilenberg, 1998; Khalafalla and Al-Mawly, 2020). Free flagella are always visible, with an average length of 11.13 μm (7.97–13.97 μm). The nucleus is located in the middle of the body, with an average ratio of 1.46 (0.97–2.11). The posterior end varies between blunt and pointed (Fig. 3) with a conspicuous undulating membrane. Table 2. Amplification and sequencing primers and PCR programs.
Molecular identificationAmplification using the ITS1 primer revealed a single band at 480 bp in all isolates, indicating the subgenus Trypanozoon (WOAH, 2021; Suganuma et al., 2022). This identification was confirmed using the ESAG6/7 primer, which has been reported as a primer for this subgenus (WOAH, 2021). The sequence similarity of Indonesian trypanosomes based on the ESAG6 gene was highly similar (>90%) to T. brucei, T. evansi, and T. equiperdum (Table 4). This genetic evidence confirmed that the trypanosome isolates belong to the subgenus Trypanozoon, with three possible species. Species differentiation was achieved through molecular identification using Mini and then Maxi primers. Identification using Mini primers showed positive PCR results for all isolates tested, and some isolates showed positive PCR results using Maxi primers (Table 5). Mini primers amplify the minicircle gene, and Maxi primers amplify nd5 of the maxicircle gene encoding NADH dehydrogenase 5. The results of similarity analysis of the minicircle gene sequence showed high similarity (>94%) to T. evansi and T. equiperdum, and none of them were similar to T. brucei (Table 6). Phylogenetic analysis based on the minicircle gene sequence also proved that the Mini primers were able to clearly separate the T. brucei group from T. evansi and T. equiperdum (Fig. 4).
Fig. 3. Microscopic photograph of the subgenus Trypanozoon from Indonesia. (A, B) Jateng3 isolates that have been identified as T. equiperdum. (C, D) NTT isolates that have been identified as T. evansi. Table 3. Morphobiometrics of Indonesian Trypanosomes (μm).
DiscussionMorphological approachThe Indonesian isolate in this study had the following characteristics: a long and slender shape; small kinetoplasts located subterminal or nearly terminal from the posterior end; the nucleus located in the middle of the body; oval, free flagella that are always clearly visible with a conspicuous undulating membrane; and the posterior end varying between blunt and pointed (Figs. 1 and 3). The morphological characteristics of the Indonesian isolate correspond to those of the subgenus Trypanozoon (Hoare, 1956; Uilenberg, 1998). The Trypanozoon is divided into three species that are morphologically very difficult to distinguish due to their similarities (Sánchez et al., 2016; Wen et al., 2016; Gizaw et al., 2017; WOAH, 2021). Table 4. Indonesian trypanosome sequence similarity based on the ESAG 6/7 gene.
Overall, the 28 Indonesian Trypanozoon had a total body length of 22.79–30.89 μm, with the position of the kinetoplast 1.82 μm (0.17–2.73 μm) from the posterior end. These morphometric characteristics are also similar to those of 17–30 or 18–34 μm for T. evansi, and 20–30 μm for T. equiperdum (Hoare, 1956; Uilenberg, 1998; Ahmed et al., 2018). Variation in total body length can overlap across species, and all Indonesian trypanosomes fall within this range. Biologically, Hoare (1956) has provided guidance that T. brucei can be distinguished from non-T. brucei based on two characteristics: (i) T. brucei also often exhibits a stumpy form, and (ii) the presence of tsetse flies as vectors in its life cycle. Members of the subgenus Trypanozoon other than T. brucei do not possess either of these characteristics: (i) no Indonesian isolates were found to exhibit the stumpy form of their original host, and (ii) the tsetse fly (Glossina sp.) has not been found in Indonesia. Biologically, therefore, Trypanosoma isolates from Indonesia tend to be T. evansi or T. equiperdum, as indicated above. However, because T. brucei, T. evansi, and T. equiperdum are morphologically indistinguishable, molecular approaches are needed to resolve the difficulty of species differentiation. Table 5. Amplification results of PCR using five primer sets.
Molecular approachTaxonomy has traditionally been based on morphological differences, but species identification based on morphology is not without pitfalls, as encountered in the subgenus Trypanozoon in this study. On the other hand, molecular identification is now widespread and highly developed, although it is unfortunate that some researchers take shortcuts and ignore the morphological approach (which will lead to bias in trypanosome classification). In this study, we used both approaches to reduce the gap between the methods and the weaknesses of each method. The basic concept underlying this study is a multistage molecular identification algorithm, as illustrated in Figure 1. The first stage of screening using the ITS1 primer, an amplicon of 480 bp indicated that the trypanosome is a subgenus of Trypanozoon (Isaac et al., 2016; Odongo et al., 2016; Alanazi et al., 2018; Elata et al., 2020). This step was further confirmed by amplification using ESAG6/7 primers to obtain 237-bp amplicons referring to the subgenus Trypanozoon (Holland et al., 2001; WOAH, 2021; Jaimes-Dueñez et al., 2022). Overall, these results reinforce the morphological identification that proves that all Indonesian isolates are in the subgenus Trypanozoon. The key to species identification in the subgenus Trypanozoon relies on the presence of the minicircle and maxicircle genes. The maxicircle gene is related to the regulation of Trypanozoon development and differentiation in the vectors, while the minicircle encodes a guide RNA (gRNA) related to the decoding and post-transcriptional editing of the maxicircle (Gizaw et al., 2017; Cooper et al., 2022). Trypanosoma brucei has kDNA with full-size maxicircle and heterogeneous minicircle genes, while T. equiperdum is known to have full or partial-size maxicircle and homogeneous minicircle genes (Gizaw et al., 2017). Trypanosoma evansi has kDNA with homogenous minicircle and completely lost maxicircle genes (Gizaw et al., 2017). Mini primers were designed to amplify the locus gRNA in the minicircle gene (Table 2) to distinguish between T. evansi and T. brucei (Artama et al., 1992). However, the sequencing results of these amplicons (357 bp) revealed two possibilities with high similarity to the minicircle genes of T. evansi and T. equiperdum (Subekti et al., 2023). In this study, similar results were obtained (Table 6) and supported by phylogenetic analysis that clearly separated the T. brucei group from the T. evansi–T. equiperdum group, as shown in Figure 4. A positive PCR result at this stage eliminates T. brucei and leaves only two species (T. evansi and T. equiperdum). Trypanosoma evansi still shows a negative PCR result when amplified using Maxi primers (Li et al., 2007) because the maxicircle gene is completely lost (Gizaw et al., 2017). Therefore, primers targeting this gene can differentiate T. evansi from T. brucei and T. equiperdum. The primers were targeted to amplify the nd5 locus of the maxicircle gene and were reported to have high similarity to T. equiperdum and T. brucei (Table 6). Although the maxicircle gene in some T. equiperdum isolates is deletion, the nd5 gene still exists (Shu and Stuart, 1994). In this study, two different groups were obtained: the negative and positive maxicircle groups (Table 5). The negative maxicircle group was identified as T. evansi, considering that the trypanosome is a member of the subgenus Trypanozoon, which only has a minicircle gene. The maxicircle-positive group was identified as T. equiperdum on the basis that the possibility of it being T. brucei was eliminated at the previous stage. Therefore, members of the subgenus Trypanozoon that showed positive results for the minicircle and maxicircle genes were T. equiperdum, as described in Figure 1. Table 6. Indonesian trypanosome sequence similarity based on minicircle and maxicircle genes.
Another approach used HCA based on PCR data using four primer pairs, namely ESAG6/7, Mini, Maxi, and RoTat (Table 5). The cladogram of the HCA analysis successfully and clearly separated Indonesian isolates into T. evansi and T. equiperdum groups (Fig. 5). Furthermore, T. equiperdum was also separated into two subgroups: RoTat positive and negative. Our results were consistent with other similar findings based on serological tests for the presence of T. equiperdum, which did not express RoTat 1.2 VSG (Claes et al., 2004). Trypanosoma evansi has also been reported to have three subgroups based on positive and negative PCR of the RoTat gene and was thus divided into genotypes A, B, and non-A/B (Birhanu et al., 2016; Behour and El-Fattah, 2023; Subekti et al., 2024b). In general, it can be concluded that there are 12 Indonesian isolates identified as T. evansi having a total body length of 26.44 μm (22.79–29.04 μm) with the kinetoplast position at a distance of 1.74 μm from the posterior end (Table 7), compared to 17–30 or 18–34 μm for the length of T. evansi in general. The remaining 16 Indonesian isolates were identified as T. equiperdum with a total body length of 26.43 μm (22.83–30.89 μm) and a kinetoplast position at 1.88 μm from the posterior end (Table 8) compared to 20–30 μm for the length of T. equiperdum in general.
Fig. 4. Phylogenetic tree of Indonesian trypanosomes based on minicircle gene sequences constructed by UPGMA with nucleotide distance measure Kimura-80 and a bootstrap analysis of 1,000 replicates. Based on the current genomic understanding of trypanosomes, T. evansi and T. equiperdum can be distinguished based on the presence of maxicircle genes in their kinetoplasts. In this study, the design of a multistage molecular identification algorithm combined with a morphobiological approach allowed us to distinguish the species of the subgenus Trypanozoon. Although it still has shortcomings, it is open to improvement. One of the objections was related to the opinion of the existence of akinetoplastic T. evansi and T. equiperdum. Both trypanosomes that did not have kDNA were grouped into the akinetoplastic Trypanozoon, which was suggested to be named differently. Referring to the opinion of Hoare (1956), who divided the Trypanozoon into groups, namely the T. brucei group (T.b. brucei, T.b. gambiense, and T.b. rhodesiense) and the T. evansi group (T. evansi, T. equiperdum, and T. equinum), it is recommended to consider adjusting the name of the latter group. It is proposed that members of the T. evansi group may be considered for a change to Trypanosoma evansi evansi (T.e. evansi), T.e. equiperdum, and T.e. equinum as a group of mechanical or non-tsetse-transmissible Trypanozoon groups. T.e. equinum is a new name historically proposed for the akinetoplastic Trypanozoon. Challenges in identificationOne of the challenges in this study was the presence of isolates that were widely believed to be T. evansi. The cause of this misidentification was due to relying only on morphological observations. Misidentification is also due to misinformation regarding the use of the primers ESAG6/7 and RoTat 1.2, which are considered specific only for T. evansi, whereas both primers are specific to the subgenus level. This example is Trypanosoma with the designation RoTat 1.2, which has been widely used as a standard isolate for T. evansi (Ngaira et al., 2004). This original isolate was obtained from Indonesia and is currently maintained in our laboratory. This corresponds to the Jabar1 isolate that has been detected to have the maxicircle gene, so it should be identified as T. equiperdum. If it is still regarded as T. evansi, then the theory that T. evansi lacks the minicircle gene must be evaluated, although this will further complicate its identification and classification.
Fig. 5. Cladogram constructed with HCA using the complete linkage method (farthest neighbor clustering). Table 7. Indonesian isolate that has been identified as Trypanosoma evansi (μm).
An Indonesian isolate designation as RoTat 1.2 (corresponds to Jabar1) was isolated from a buffalo at an abattoir in Bogor, West Java province, in 1982. The buffalo is known to have originated in Pekalongan, Central Java province, Indonesia. Historically, this isolate was initially identified as T. evansi based only on morphological features and has remained so to date, followed by molecular identification using RoTat primers. It is known that the RoTat primers are only suitable for the identification of the Trypanozoon subgenus level and cannot be used for species differentiation when used independently (WOAH, 2021). Therefore, we recommend adopting an integrated identification approach that incorporates morphological observation, biometric analysis, and molecular identification algorithms, as demonstrated in this study. Such an approach is necessary to minimize the risk of misidentification. Table 8. Indonesian isolate that has been identified as Trypanosoma equiperdum (μm).
ConclusionThe morphological and molecular identification algorithms carried out in stages using ITS1, ESAG6/7, Minicircle, and Maxicircle primers are extremely promising for identifying Trypanozoon species. The use of minicircle and maxicircle primers is key to distinguishing T. evansi and T. equiperdum. The Indonesian isolates from this study were T. evansi with a total body length of 22.79–29.04 μm and T. equiperdum with a total body length of 22.83–30.89 μm. The Jabar1 isolate (RoTat 1.2), originally isolated in Indonesia, may not, in fact, be T. evansi, as has long been assumed by researchers, given its possession of the maxicircle gene. This observation raises the possibility that morphological analysis alone is inadequate for accurate species identification. A more integrative approach that combines morphological assessment with molecular identification algorithms is likely to yield more robust and reliable results. AcknowledgmentsWe would like to express our sincere gratitude to our previous institute, the Indonesian Research Center for Veterinary Science, Bogor, Indonesia, for the opportunity to conduct the study using the trypanosome collection stored in their culture collection (Balitvet Culture Collection). We also appreciate Ardi Martono, who helped with the morphological measurements of trypanosomes. Conflict of interestThe authors declare that they have no conflicts of interest. FundingAgricultural Research and Development Agency, Indonesian Ministry of Agriculture for providing a research grant through the Innovative and Collaborative Development Research scheme (number: 58/Kpts/OT.050/H.5/04/2021) to DTS and a research grant from the Directorate of Research, Technology, and Community Service and the Directorate General of Higher Education, Research, and Technology through the Institute for Research and Community Service at Airlangga University (number: 1268/UN3.LPPM/PT.01.03/2023) to LTS. Author’s contributionDTS, research design, data acquisition, analysis, writing, and submitting the manuscript. LTS, SS, MM, research design, supervision, and reviewing the manuscript. ES, ISH, EBAH, EKS, reviewing the manuscript. Ethical approvalAll experiments using mice were conducted according to and approved by the Experimental Animal Ethics Commission of the Indonesian Agricultural Research and Development Agency (approval number Balitbangtan/BB Litvet/Rd/06/2021) Data availabilityAll data were provided in the manuscript. ReferencesAhmed, Y., Hagos, A., Merga, B., Van Soom, A., Duchateau, L., Goddeeris, B. and Govaere, J. 2018. Trypanosoma equiperdum in the horse—a neglected threat? Vlaams Diergen. Tijds. 87(2), 66–75. Alanazi, A.D., Puschendorf, R., Salim, B., Alyousif, M.S., Alanazi, I.O. and Al-Shehri, H.R. 2018. Molecular detection of equine trypanosomiasis in the Riyadh Province of Saudi Arabia. J. Vet. Diagn. Invest. 30(6), 942–945. Artama, W.T., Agey, M.W. and Donelson, J.E. 1992. DNA comparisons of Trypanosoma evansi (Indonesia) and Trypanosoma brucei spp. Parasitology 104, 6774. Austen, J.M. and Barbosa, A.D. 2021. Diversity and epidemiology of bat trypanosomes: a one health perspective. Pathogens 10(9), 1148.– Baral, T.N. 2010. Immunobiology of African trypanosomes: need of alternative interventions. J. Biotechnol. Biomed. 2010, 389153. Behour, T.S. and El-Fattah, E.M.A. 2023. Genotyping of Trypanosoma brucei evansi in Egyptian camels: detection of a different non-RoTat 1.2 Trypanosoma brucei evansi in Egyptian camels. Trop. Anim. Health Pro. 55(4), 279. Benfodil, K., Büscher, P., Abdelli, A., Van Reet, N., Mohamed-Herif, A., Ansel, S., Fettata, S., Dehou, S., Bebronne, N., Geerts, M., Balharbi, F. and Ait-Oudhia, K. 2020. Comparison of serological and molecular tests for detection of Trypanosoma evansi in domestic animals from Ghardaïa district, South Algeria. Vet. Parasitol. 280, 109089. Birhanu, H., Gebrehiwot, T., Goddeeris, B.M., Büscher, P. and Van Reet, N. 2016. New Trypanosoma evansi type B isolates from Ethiopian dromedary camels. PLoS Negl. Trop. Dis. 10(4), e0004556. Bono-Battistoni, M.F., Orcellet, V., Peralta, J.L., Marengo, R., Plaza, D., Brunini, A., Ruiz, M., Widenhorn, N., Sanchez, A., Monje, L. and Cignetti, L. 2016. First report of Trypanosoma evansi in a canine in Argentina. Vet. Parasitol. Reg. Stud. Rep. 6, 1–3. Boutellis, A., Bellabidi, M., Benaissa, M.H., Harrat, Z., Brahmi, K., Drali, R. and Kernif, T. 2021. New haplotypes of Trypanosoma evansi identified in dromedary camels from Algeria. Acta Parasitol. 66(1), 294–302. Bruce, D. 1911. The morphology of Trypanosoma evansi (Steel). Proc. R. Soc. B Biol. Sci. 84, 181–187. Claes, F., Radwanska, M., Urakawa, T., Majiwa, P.A., Goddeeris, B. and Büscher, P. 2004. Variable surface glycoprotein RoTat 1.2 PCR as a specific diagnostic tool for the detection of Trypanosoma evansi infections. Kinetoplastid Biol. Dis. 3, 3. Cooper, S., Wadsworth, E.S., Schnaufer, A. and Savill, N.J. 2022. Organization of minicircle cassettes and guide RNA genes in Trypanosoma brucei. RNA 28, 972–992. Dangolla, A., Wijesundara, D.L.R., Blair, D., Fernando, D.D., Wijesundera, K.K., Chathuranga, W.G.D., de Silva, W.A.P.P. and Rajakaruna, R.S. 2020. Canine trypanosomosis in Sri Lanka: an emerging problem reported from three distinct geographic locations. Parasitol. Int. 77, 102129. Desquesnes, M., Gonzatti, M., Sazmand, A., Thévenon, S., Bossard, G., Boulangé, A., Gimonneau, G., Truc, P., Herder, S., Ravel, S., Sereno, D., Jamonneau, V., Jittapalapong, S., Jacquiet, P., Solano, P. and Berthier, D. 2022. A review on the diagnosis of animal trypanosomoses. Parasite Vector 15(1), 64. Dewi, R.S., Damajanti, R., Wardhana, A.H., Mulatsih, S., Poetri, O.N., Steeneveld, W. and Hogeveen H. 2020. The economic losses of Surra outbreak in Sumba Timur, Nusa Tenggara Timur-Indonesia. Trop. Anim. Sci. J. 43(1), 77–85. Elata, A., Mossaad, E., Satti, R., Matar, N., Ohari, Y., Xuan, X., Inoue, N. and Suganuma, K. 2020. Serological and molecular detection of selected hemoprotozoan parasites in donkeys in West Omdurman, Khartoum State, Sudan. J. Vet. Med. Sci. 82(3), 286–293. Gaithuma, A.K., Yamagishi, J., Martinelli, A., Hayashida, K., Kawai, N., Marsela, M. and Sugimoto, C. 2019. A single test approach for accurate and sensitive detection and taxonomic characterization of Trypanosomes by comprehensive analysis of internal transcribed spacer 1 amplicons. PLoS Negl. Trop. Dis. 13(2), e0006842. Gizaw, Y., Marsela, M. and Fayera, T. 2017. Dourine: a neglected disease of equids. Trop. Anim. Health Pro. 49, 887–897. Habeeb, I.F., Chechet, G.D. and Kwaga, J.K.P. 2021. Molecular identification and prevalence of trypanosomes in cattle distributed within the Jebba axis of the River Niger, Kwara state, Nigeria. Parasite Vector 14(1), 560. Hoare, C.A. 1956. Morphological and taxonomic studies on mammalian trypanosomes. Parasitology 46, 130–172. Holland, W.G., Claes, F., My, L.N., Thanh, N.G., Tam, P.T., Verloo, D., Büscher, P., Goddeeris, B. and Vercruysse, J. 2001. A comparative evaluation of parasitological tests and a PCR for Trypanosoma evansi diagnosis in experimentally infected water buffaloes. Vet. Parasitol. 97, 23–33. Isaac, C., Ciosi, M., Hamilton, A., Scullion, K.M., Dede, P., Igbinosa, I.B., Nmorsi, O.P., Masiga, D. and Turner, C.M. 2016. Molecular identification of different trypanosome species and subspecies in tsetse flies of northern Nigeria. Parasite Vector 9, 301. Jaimes-Dueñez, J.E., Jiménez-Leaño, Á.P., Montenegro-Ayala, D. and Esteban-Mendoza, M. 2022. Understanding the epidemiology of Trypanosoma evansi infection in dogs (Canis lupus familiaris) from urban areas of Colombia. Am. J. Anim. Vet. Sci. 7(2), 180–186. Khalafalla, R.E. and Al-Mawly, J.H. 2020. Biometrical and morphological description of Trypanosoma evansi among one-humped camel (Camelus dromedarius) in Oman. J. Saudi. Soc. Agric. Sci. 19, 326–331. Li, F.J., Lai, D.H., Lukeš, J., Chen, X.G. and Lun, Z.R. 2006. Doubts about Trypanosoma equiperdum strains classed as Trypanosoma brucei or Trypanosoma evansi. Trends Parasitol. 22, 55–56. Li, F.J., Gasser, R.B., Lai, D.H., Claes, F., Zhu, X.Q. and Lun, Z.R. 2007. PCR approach for the detection of Trypanosoma brucei and T. equiperdum and their differentiation from T. evansi based on maxicircle kinetoplast DNA. Mol. Cell. Probes. 21, 1–7. Magri, A., Galuppi, R. and Fioravanti, M. 2021. Autochthonous Trypanosoma spp. in European mammals: a brief journey amongst the neglected Trypanosomes. Pathogens 10(3), 334. Marsela, M., Hayashida, K., Nakao, R., Chatanga, E., Gaithuma, A.K., Naoko, K., Musaya, J., Sugimoto, C. and Yamagishi, J. 2020. Molecular identification of trypanosomes in cattle in Malawi using PCR methods and nanopore sequencing: epidemiological implications for the control of human and animal trypanosomiases. Parasite 27, 46. Ngaira, J.M., Njagi, E.N., Ngeranwa, J.J. and Olembo, N.K. 2004. PCR amplification of RoTat 1.2 VSG gene in Trypanosoma evansi isolates in Kenya. Vet. Parasitol. 120, 23–33. Njiru, Z.K., Constantine, C.C., Guya, S., Crowther, J., Kiragu, J.M., Thompson, R.C.A. and Dávila, A.M.R. 2005. The use of ITS1 rDNA PCR in detecting pathogenic African trypanosomes. Parasitol. Res. 95, 186–192. Odongo, S., Delespaux, V., Ngotho, M., Bekkele, S.M. and Magez, S. 2016. Comparative evaluation of the nested ITS PCR against the 18S PCR-RFLP in a survey of bovine trypanosomiasis in Kwale County, Kenya. J. Vet. Diagn. Invest. 28(5), 589–594. Oldrieve, G., Verney, M., Jaron, K.S., Hébert, L. and Matthews, K.R. 2021. Monomorphic Trypanozoon: towards reconciling phylogeny and pathologies. Microb. Genom. 7(8), 000632. Ortiz-Martínez, Y., Kouamé, M.G., Bongomin, F., Lakoh, S. and Henao-Martínez, A.F. 2023. Human African trypanosomiasis (sleeping sickness)—epidemiology, clinical manifestations, diagnosis, treatment, and prevention. Curr. Trop. Med. Rep. 10, 222–234. Richardson, J.B., Lee, K-Y., Mireji, P., Enyaru, J., Sistrom, M., Aksoy, S., Zhao, H. and Caccone, A. 2017. Genomic analyses of African Trypanozoon strains to assess evolutionary relationships and identify markers for strain identification. PLoS Negl. Trop. Dis. 11(9), e0005949. Salah, A.A., Robertson, I. and Mohamed, A. 2015. Estimating the economic impact of Trypanosoma evansi infection on production of camel herds in Somaliland, 2015. Trop. Anim. Health Prod. 47, 707–714. Sánchez, E., Perrone, T.M., Sánchez, F. and Mijares, A. 2016. Kinetoplast ultrastructure of five Trypanosoma evansi and Trypanosoma equiperdum Venezuelan isolates. Acta Microsc. 25, 143–150. Sawitri, D.H., Wardhana, A.H., Wibowo, H., Sadikin, M. and Ekawasti, F. 2015. Molecular identification technique of Trypanosoma evansi by multiplex polymerase chain reaction. Indones. J. Anim. Vet. Sci. 20(4), 297–307. Setiawan, A., Nurcahyo, W., Priyowidodo, D., Budiati, R.T. and Susanti, D.S.R. 2021. Genetic and parasitological identification of Trypanosoma evansi infecting cattle in South Sulawesi, Indonesia. Vet. World 14(1), 113–119. Shu, H.H. and Stuart, K. 1994. Mitochondrial transcripts are processed but are not edited normally in Trypanosoma equiperdum (ATCC 30019) which has kDNA sequence deletion and duplication. Nucleic Acids Res. 22(9), 1696–1700. Subekti, D.T., Ekawasti, F., Azmi, Z., Yuniarto, I., Fong, S. and Fahrimal, Y. 2023. Does Trypanosoma evansi have the maxicircle gene, or can Trypanosoma equipedum be isolated from bovine? J Parasitol. 109(4), 436–444. Subekti, D.T., Azmi, Z., Kurniawati, D.A., Suwanti, L.T., Mufasirin, M. and Sunarno, S. 2024a. Molecular characterization of trypanocides-resistant strains derived from a single field isolate of Trypanosoma evansi. Vet. Parasitol. 330, 110236. Subekti, D.T., Suwanti, L.T., Kurniawati, D.A., Mufasirin, M. and Sunarno, S. 2024b. Molecular identification of new Trypanosoma evansi type non-A/B isolates from buffaloes and cattle in Indonesia. Rev. Bras. Parasitol. Vet. 33(2), e001324. Subekti, D.T., Fong, S., Kurniawati, D.A., Jannah, N., Yuniarto, I., Suwanti, L.T., Sunarno, S., Mufasirin, M. and Rohman, A. 2025. Nucleic acid amplification-lateral flow immunoassay (NAA-LFIA) for the rapid differentiation of Trypanosoma evansi and Trypanosoma equiperdum. Vet J. 310, 106306. Suganuma, K., Acosta, T.J., Valinotti, M.F.R., Sanchez, A.R., Mossaad, E., Elata, A. and Inoue, N. 2022. First molecular survey of animal trypanosomes in Paraguayan horses. Vet. Parasitol. Reg. Stud. Rep. 27, 100664. Uilenberg, G.A. 1998. Field guide for the diagnosis, treatment, and prevention of African animal trypanosomosis. Rome, Italy: Food and Agriculture Organization of The United Nations. Wen, Y.Z., Lun, Z.R., Zhu, X.Q., Hide, G. and Lai, D.H. 2016. Further evidence from SSCP and ITS DNA sequencing support Trypanosoma evansi and Trypanosoma equiperdum as subspecies or even strains of Trypanosoma brucei. Infect. Genet. Evol. 41, 56–62. World Organization of Animal Health (WOAH). 2021. Surra in all species (Trypanosoma evansi infection). OIE Terrestrial Manual 2021, Chapter 3.1.20, pp: 1–15. | ||
| How to Cite this Article |
| Pubmed Style Subekti DT, Suwanti LT, Sunarno S, Mufasirin M, Suprihati E, Hamid IS, Herupradoto EBA, Sabdoningrum EK. Morphometrics analysis and molecular identification of the Trypanozoon from Indonesia. Open Vet. J.. 2025; 15(7): 3254-3268. doi:10.5455/OVJ.2025.v15.i7.36 Web Style Subekti DT, Suwanti LT, Sunarno S, Mufasirin M, Suprihati E, Hamid IS, Herupradoto EBA, Sabdoningrum EK. Morphometrics analysis and molecular identification of the Trypanozoon from Indonesia. https://www.openveterinaryjournal.com/?mno=240539 [Access: January 25, 2026]. doi:10.5455/OVJ.2025.v15.i7.36 AMA (American Medical Association) Style Subekti DT, Suwanti LT, Sunarno S, Mufasirin M, Suprihati E, Hamid IS, Herupradoto EBA, Sabdoningrum EK. Morphometrics analysis and molecular identification of the Trypanozoon from Indonesia. Open Vet. J.. 2025; 15(7): 3254-3268. doi:10.5455/OVJ.2025.v15.i7.36 Vancouver/ICMJE Style Subekti DT, Suwanti LT, Sunarno S, Mufasirin M, Suprihati E, Hamid IS, Herupradoto EBA, Sabdoningrum EK. Morphometrics analysis and molecular identification of the Trypanozoon from Indonesia. Open Vet. J.. (2025), [cited January 25, 2026]; 15(7): 3254-3268. doi:10.5455/OVJ.2025.v15.i7.36 Harvard Style Subekti, D. T., Suwanti, . L. T., Sunarno, . S., Mufasirin, . M., Suprihati, . E., Hamid, . I. S., Herupradoto, . E. B. A. & Sabdoningrum, . E. K. (2025) Morphometrics analysis and molecular identification of the Trypanozoon from Indonesia. Open Vet. J., 15 (7), 3254-3268. doi:10.5455/OVJ.2025.v15.i7.36 Turabian Style Subekti, Didik Tulus, Lucia Tri Suwanti, Sunarno Sunarno, Mufasirin Mufasirin, Endang Suprihati, Iwan Sahrial Hamid, Eduardus Bimo Aksono Herupradoto, and Emy Koestanti Sabdoningrum. 2025. Morphometrics analysis and molecular identification of the Trypanozoon from Indonesia. Open Veterinary Journal, 15 (7), 3254-3268. doi:10.5455/OVJ.2025.v15.i7.36 Chicago Style Subekti, Didik Tulus, Lucia Tri Suwanti, Sunarno Sunarno, Mufasirin Mufasirin, Endang Suprihati, Iwan Sahrial Hamid, Eduardus Bimo Aksono Herupradoto, and Emy Koestanti Sabdoningrum. "Morphometrics analysis and molecular identification of the Trypanozoon from Indonesia." Open Veterinary Journal 15 (2025), 3254-3268. doi:10.5455/OVJ.2025.v15.i7.36 MLA (The Modern Language Association) Style Subekti, Didik Tulus, Lucia Tri Suwanti, Sunarno Sunarno, Mufasirin Mufasirin, Endang Suprihati, Iwan Sahrial Hamid, Eduardus Bimo Aksono Herupradoto, and Emy Koestanti Sabdoningrum. "Morphometrics analysis and molecular identification of the Trypanozoon from Indonesia." Open Veterinary Journal 15.7 (2025), 3254-3268. Print. doi:10.5455/OVJ.2025.v15.i7.36 APA (American Psychological Association) Style Subekti, D. T., Suwanti, . L. T., Sunarno, . S., Mufasirin, . M., Suprihati, . E., Hamid, . I. S., Herupradoto, . E. B. A. & Sabdoningrum, . E. K. (2025) Morphometrics analysis and molecular identification of the Trypanozoon from Indonesia. Open Veterinary Journal, 15 (7), 3254-3268. doi:10.5455/OVJ.2025.v15.i7.36 |